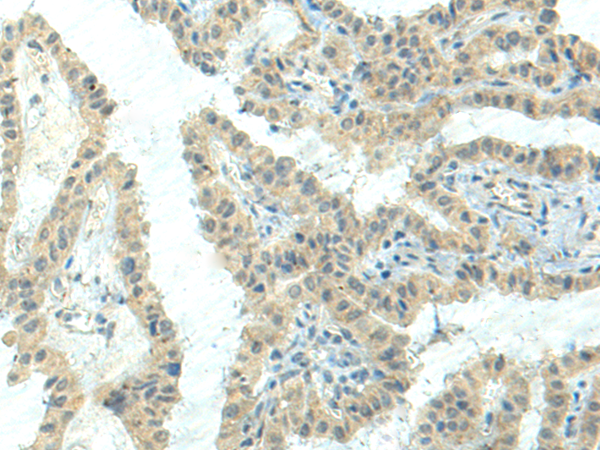

中文名稱: 兔抗NPVF多克隆抗體
英文名稱: Anti-NPVF rabbit polyclonal antibody
別 名: neuropeptide VF precursor; RFRP; C7orf9
相關類別: 一抗
儲 存: 冷凍(-20℃)
宿 主: Rabbit
抗 原: NPVF
反應種屬: Human
標 記 物: Unconjugate
克隆類型: rabbit polyclonal
技術規(guī)格
|
Background: |
Neuropeptide RFRP-1 acts as a potent negative regulator of gonadotropin synthesis and secretion. Neuropeptides NPSF and NPVF efficiently inhibit forskolin-induced production of cAMP, but RFRP-2 shows no inhibitory activity. Neuropeptide RFRP-1 induces secretion of prolactin in rats. Neuropeptide NPVF blocks morphine-induced analgesia. |
|
Applications: |
ELISA, IHC |
|
Name of antibody: |
NPVF |
|
Immunogen: |
Synthetic peptide of human NPVF |
|
Full name: |
neuropeptide VF precursor |
|
Synonyms: |
RFRP; C7orf9 |
|
SwissProt: |
Q9HCQ7 |
|
ELISA Recommended dilution: |
5000-10000 |
|
IHC positive control: |
Human ovarian cancer and Human thyroid cancer |
|
IHC Recommend dilution: |
50-300 |

購物車
幫助
021-54845833/15800441009
